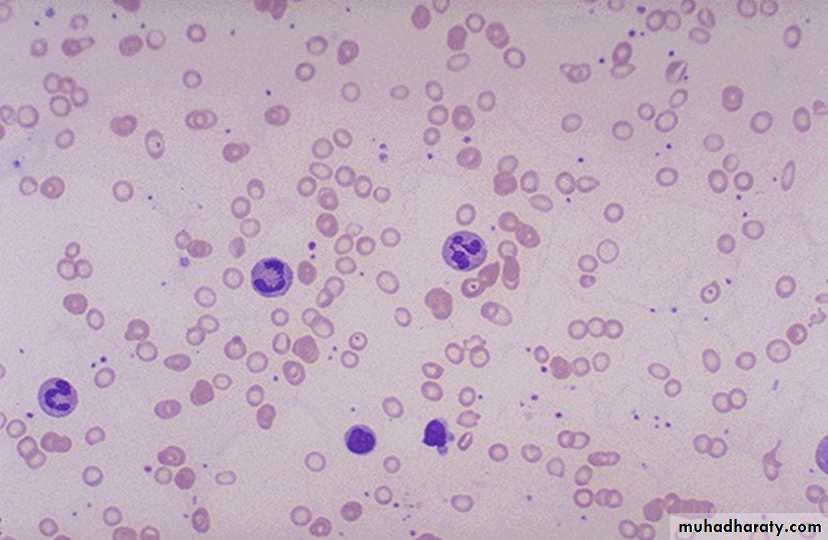

بسم الله الرحمن الرحيم
Lecture twoHemoglobin By Dr. Suroor Mohamed Objectives
Describe the normal structure of hemoglobin “ Hb”.What is the function of Hb in our body ?
What is mean by hemoglobinopathy?
Define Anemia & its type .
:Hemoglobin structure
The red, oxygen-carrying pigment in the RBCs is hemoglobin, a protein with a molecular weight of 64,450. Hb is a globular molecule made up of 4 subunits .Each subunit contains a heme moiety conjugated to a polypeptide. Heme is an iron-containing derivative while the polypeptides are referred to the globin portion of the hemoglobin molecule .There are two pairs of polypeptides in each hemoglobin molecule.
1. (hemoglobin A is α2 β2 ) the normal adult human hemoglobin ; the two types of polypeptide are called the α chains, each of which contains 141 amino acid residues, and the β chains, each of which contains 146 amino acid residues. Thus, hemoglobin A is designated α2β2.2. hemoglobin A2 (α2δ2). this forms about 2.5% of the hemoglobin, in which β chains are replaced by δ chains (α2δ2). The δ chains also contain 146 amino acid residues, but 10 individual residues differ from those in the β chains. 3.There are small amounts of hemoglobin A derivatives closely associated with hemoglobin A that represent glycated hemoglobins., hemoglobin A1c (HbA1c), has a glucose attached to the terminal valine in each β chain and is of special interest because the quantity in the blood increases in poorly controlled diabetes mellitus .
4.Hemoglobin in the Fetus 1.The blood of the human fetus normally contains fetal hemoglobin (hemoglobin F hemoglobin F is( α2 γ2). The γ chains also contain 146 amino acid residues but have 37 that differ from those in the β chain. Fetal hemoglobin is normally replaced by adult hemoglobin soon after birth. In the body, its O2 content at a given PO2 is greater than that of adult hemoglobin , this facilitates movement of O2 from the maternal to the fetal circulation
2. In early embryonic life there are, ζ and ε chains, forming Gower 1 hemoglobin (ζ2ε2) and Gower 2 hemoglobin (α2ε2).
• The normal hemoglobin content of blood is 16 g/dL in men and 14 g/dL in women, all of it in red cells.
Function of Hb
*Carriage of O2Hb reversibly bind O2 to form oxyhemoglobin affect by pH, temperature, H + concentration
*Carriage of CO2
Hb bind CO2 = carboxyhemaglobin
*Buffer system
Adult HB
Oxy & deoxyhaemoglobin
• Abnormality in the polypeptide chain - abnormal Hb (hemoglobinopathies) e.g thalassemias, sickle cell
The amino acid sequences in the polypeptide chains of hemoglobin are determined by globin genes. There are two major types of inherited disorders the hemoglobinopathies, as the * thalassemias disorders, the chains are normal in structure but produced in decreased amounts or absent because of defects in the regulatory portion of the globin genes.Alpha globin chains are produced by 2genes on chromosome 16 and beta globin chain by single gene on chromosme 11
The α thalassemias are defined by decreased or absent α polypeptides. The β thalassemias are defined by decreased or absent α and β polypeptides.
* Sickle cell disease . hemoglobin S, the α chains are normal but the β chains are abnormal, because among the 146 amino acid residues in each β polypeptide chain, one glutamic acid residue has been replaced by a valine residue .
When an abnormal gene inherited from one parent dictates formation of an abnormal hemoglobin—ie, when the individual is heterozygous—half the circulating hemoglobin is abnormal and half is normal. When identical abnormal genes are inherited from both parents, the individual is homozygous and all of the hemoglobin is abnormal. It is theoretically possible to inherit two different abnormal hemoglobins, one from the father and one from the mother.
hemoglobin S polymerizes at low O2 tensions, it forms elongated crystals inside the RBCs that not allowed to pass through tiny capillaries with the spiked ends of the crystals that lead to rupture the cell membranes( hemolyze) , form aggregates that block blood vessels and cause to sickle cell anemia.
The result is the severe hemolytic anemia known as sickle cell anemia, homozygous individuals develop the sickle crisis . The sickle cell gene is an example of a gene that has persisted and spread in the population. Hemoglobin F has the ability to decrease the polymerization of deoxygenated hemoglobin S, and hydroxyurea causes hemoglobin F to be produced in children and adults.
Destruction of Hemoglobin.
When red blood cells burst and release their hemoglobin, the hemoglobin is phagocytized almost immediately by macrophages in many parts of the body, but especially by the Kupffer cells of the liver and macrophages of the spleen and bone marrow. During the next few hours to days, the macrophages release iron from the hemoglobin and pass it back into the blood, to be carried by transferring either to the bone marrow for the production of new red blood cells or to the liver and other tissues for storage in the form of ferritin.Red cells at the end of their lifespan are phagocytosed by the reticulo-endothelial system.Amino acids from globin chains are recycled and iron is removed from haem for reuse in Hb synthesis. The remnant haem structure is degraded to bilirubin and conjugated to glucouronic acid before being excreted into bile.In small bowel, bilirubin is converted to stercobilin and most of this is excreted in a stool but a small amount is reabsorbed and excreted by the kidney as urobilinogen.
• Fate of Hemoglobin
• • Heme is degraded to a yellow pigment called bilirubin
• • The liver secretes bilirubin into the intestines as bile
• • The intestines metabolize it into urobilinogen
• • This degraded pigment leaves the body in feces, in a pigment called stercobilin
• • Globin is metabolized into amino acids and is released into the circulation
Any disorder that leads to blood loss , affects erythopoiesis or accelerates RBC destruction (hemolysis) will result in anemia. Anemia manifests as pallor, easy fatigability, dizziness and may result in CVS and CNS effects. Hemolytic anemia is usually associated with Jaundice.
Anemia is considered a manifestation of different diseases and not a disease itself.
• Iron metabolism
• Iron is needed for the synthesis of haemoglobin, myoglobin cytochrome oxsidase, peroxidase & catalase( heame iron)
• Total Iron in the body = 4-5g
• 65% ….. Haemoglobin
• 5% …….. other hems( myoglobin)
• 1% ……. bound to transferrin (betaglobulin) in blood
• 15-30% …… stored iron in the form of ferritin in the liver, spleen and bone marrow.
• Iron absorption
• Iron in food mostly in oxidized form (Ferric, F+3)
• Better absorbed in reduced form (Ferrious, F+2 )mainly in duodenum part of small intestine.
• Iron in stomach is reduced by gastric acid, Vitamin C.
• Rate of iron absorption depend on the amount of iron stored
• * Recommended dietary allowance 10-15 mg , 10-50 mg in the diet (only 10-15% is normally absorbed)
• Transport and storage of iron
• Iron is transport in plasma in the form of Transferrin (apotransferrin+iron)• Iron is stored in two forms
• Ferritin (apoferritin+iron)
• Haemosiderin (insoluble complex molecule, in liver, spleen, bone marrow)
• Daily loss of iron is 0.6 mgm in male & 1.3mgm/day in females
Iron overload causes hemosiderin to accumulate in the tissues, producing hemosiderosis. Large amounts of hemosiderin can damage tissues, causing hemochromatosis. This syndrome is characterized by pigmentation of the skin, pancreatic damage with diabetes ("bronze diabetes"), cirrhosis of the liver, a high incidence of hepatic carcinoma, and gonadal atrophy.
• Anaemia is the term given to the reduction in the:
• - number of erythrocytes, or• - concentration of hemoglobin and/or
• haematocrit as long as the total blood volume is normal.
• It can be a result of decreased erythrocytes production or rapid erythrocytes loss.
Anemias:
Anemia means deficiency of hemoglobin in the blood, which can be caused by either too few red blood cells or too little hemoglobin in the cells.A.Defeciency of substrates which are necessary for RBC or Hb production like:
1. Iron deficiency anaemia(increase loss* hemorhge , or decrease intake)
2.folic acid deficiency anaemia(low intake) folic a. is necessary for DNA formation and maturation of RBCs.
3 B12 defeciency anaemia. B12 is necessary for DNA formation of RBCs. defeciency due to low intake as in vegans or intrinsic factor deficiency (pernicious anaemia).
B. membrane defects as in hereditary spherocytosis or elliptocytosis.
Haemolytic anaemia eg:autoimmune Haemolytic anaemia,erythroblastosis fetalis.
C.Hemoglobinopathies.Thalassaemiaand sickle cell anaemia.
D . bone morrow infiltration like aplastic anaemia(Bone marrow aplasia means lack of functioning bone marrow, as exposed to gamma ray radiation can lead to complete destruction of bone marrow, followed in a few weeks by lethal anemia)
E. Anaemia of chronic disease .like chronic renal failure.
• Effect of anemia on circulation:
• 1.Decrease the viscosity of blood.• ( 2.Increase work load on the heart (Palpitation & Tiredness
• 3. In exercise there will be tissue hypoxia that leads to heart failure.
the erythropoietic cells of the bone marrow are the most rapidly growing and reproducing cells in the entire body for the continuing need to replenish RBCs. the maturation and rate of production of the RBCs are affected greatly by a person’s nutritional status.
vitamin B12 and folic acid are two important vitamins for final maturation of RBCs. Both of these are essential for the synthesis of DNA. , lack of either vitamin B12 and folic acid cause abnormal and diminished DNA and consequently, failure of nuclear maturation and cells division .
so the erythroblast cells of the bone marrow in addition to failure to proliferate rapidly, produce larger than normal red cells called macrocytes which are often irregular large and oval instead of the usual biconcave disc with a fragile membrane. therefore deficiency of either vitamin B12 or folic acid cause maturation failure in the process of erythropoiesis.
Failure of the absorption of vitamin B12 from the gastroitestinal tract is a common cause of RBCs maturation failure. This occurs in the disease called pernicious anaemia
Blood indices:
MCV=80-100fl Normocytic
MCH=27-31 Pg
MCHC=31-36% Normochromic
High
MacrocyticMCV
Ex:
B12 deiciency*
*Folic acid
Dificiency
*alcoholism
A 20 year old college student presented with 2 months history of increasingpallor and easy fatigability on exertion. She was previously in good health.During the 2 months she had also chronic non-bloody diarrhoea and shehad progressive weight loss. Her hemoglobin level was 8gm/dl. What is your provisional diagnosis ?
Example case :